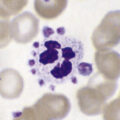

Chapter 24 Laboratory organization and management
The essential functions of a haematology laboratory are (1) to provide clinicians with timely, unambiguous and meaningful reports to assist in the clinical diagnosis of disease and to monitor response to treatment; (2) to obtain reliable and reproducible data for health screening and epidemiological studies; and (3) to keep abreast with advancing technology as well as aspects of healthcare legislation that might be relevant to modern laboratory practice. The laboratory should also be involved in both the pre-analytical stage (i.e. test ordering, blood collection, specimen transport) and the post-analytical stage (i.e. preparing reports, transmission of results and maintaining a data file).
For good laboratory practice, it is essential to have a well-structured organization with competent direction and management. The principles outlined in this chapter apply to all laboratories, irrespective of their size, although large departments are likely to require the more complex arrangements that are described.
Management structure and function
The management structure of a haematology laboratory should indicate a clear line of accountability of each member of staff to the head of department. In turn, the head of department may be managerially accountable to a clinical director (of laboratories) and thence to a hospital or health authority executive committee. The head of department is responsible for departmental leadership, for ensuring that the laboratory has authoritative representation within the hospital and for ensuring that managerial and administrative tasks are performed efficiently. Where the head of the department delegates managerial tasks to others, these responsibilities must be clearly defined and stated. Formerly, the director was usually a medically qualified haematologist, but nowadays in many laboratories, this role is being undertaken by appropriately qualified biomedical scientists, while medical haematologists serve as consultants. In that role, they should be fully conversant with the principles of laboratory practice, especially with interpretation and clinical significance of the various analytical procedures, so as to provide a reliable and authoritative link between laboratory and clinic. Furthermore, all medical staff, especially junior hospital doctors, should be invited to visit the laboratory, to see how it functions, how various tests are performed, their level of complexity, clinical utility and cost: this should give them confidence to order tests rationally, rather than automatically requesting all the tests listed on the laboratory request form.1
Management of the laboratory requires an executive committee answerable to the head of department. Under this executive, there should be a number of designated individuals responsible for implementing the functions of the department (Table 24.1).
Table 24.1 Example of components of a management structure
| Executive committee | |
| Head of department | |
| Business manager | |
| Consultant haematologist | |
| Principal scientific officer | |
| Safety officer | |
| Quality control officer | |
| Computer and data processing supervisor | |
| Sectional scientific/technical heads | |
| Cytometry | |
| Blood film morphology | |
| Immunohaematology | |
| Haemostasis | |
| Blood transfusion | |
| Special investigations (haemolytic anaemias, haemoglobinopathies, cytochemistry, molecular techniques, etc.) | |
| Clerical supervisor | |
The activities of the various members of staff clearly overlap and there must be adequate effective communication between them. There should be regular briefings at meetings of technical heads, with their section staff. The only way to avoid unauthorized ‘leakage’ of information from policy-making committees is to ensure that all members of staff are kept fully informed of any plans which might have a bearing on their careers, working practices and wellbeing.
In many countries, there are now requirements established by regulatory agencies for accreditation of laboratories and audit of their performance, as well as documents on laboratory management and practice from standards-setting authorities; there is also a plethora of guidelines from national and international professional bodies. These may indicate a need for a special sub-committee of the executive committee, whose duty it is to keep abreast of these matters, to be responsible for developing standard operating procedures (SOPs) and to inter-relate with the different sections in the same way as the safety officer.
Staff Appraisal
All members of staff should receive training to enhance their skills and to develop their careers. This requires setting of goals and regular appraisal of progress for both managerial and technical ability. The appraisal process should cascade down from the head of department and appropriate training must be given to those who undertake appraisals at successive levels. The appraiser should provide a short list of topics to the person to be interviewed, who should be encouraged to add to the list, so that each understands the items to be covered. Topics to be considered should include: quality of performance and accurate completion of assignments; productivity and dependability; ability to work in a team; and ability to relate to patients, clinicians and co-workers. It is not appropriate to include considerations relating to pay. An appraisal interview should be a constructive dialogue of the present state of development and the progress made to date; it should be open-ended and should identify future training requirements. Ideally, the staff members should leave the interviews with the knowledge that their personal development and future progress are of importance to the department; that priorities have been identified; that an action plan with milestones and a time scale has been agreed; and that progress will be monitored. Formal appraisal interviews (annually for senior staff and more often for others) should be complemented by less formal follow-up discussions to monitor progress and to check that suboptimal performance has been modified. Documentation of formal interviews can be limited to a short list of agreed objectives. Performance appraisal can have lasting value in the personal development of individuals, but the process can easily be mishandled and should not be started without training in how to hold an appraisal interview.2
Continuing Professional Development
Continuing professional development is a process of continuous systematic learning which enables health workers to be constantly brought up to date on developments in their professional work and thus ensure their competence to practice throughout their professional careers. Policies and programmes have been established in a number of countries and, in some, participation is a mandatory requirement for the right to practice.3
In the UK, clinical haematologists and clinical scientists who have the relevant qualifications awarded by the Royal College of Pathologists (RCPath) and are licenced to practice by the General Medical Council, are required to participate in a scheme organized by the College. This involves maintenance of a portfolio showing their participation in relevant educational and academic affairs and demonstrations of their professional skills.
The Institute for Biomedical Science undertakes a similar scheme for scientists/technologists working in the laboratory, which is mandatory for registration to practice by the UK Health Professions Council. The procedure is based on obtaining ‘credits’ for various activities that qualify, such as: attendance at specified lectures, workshops and conferences; giving lectures; writing books or journal articles; using computer or journal-based programmes; and taking part in peer review discussions.
Strategic and Business Planning
The head of department is responsible for determining the long-term (usually up to 5 years) strategic direction of the department. Strategic planning requires awareness of any national and local legislation that may affect the laboratory and of changes in local clinical practice that may alter workload. Expansion of a major clinical service, such as organ transplantation, or the opportunity to compete for the laboratory service of other hospitals and clinics, may pose an external opportunity, but may also be a threat to the laboratory, depending on its ability to respond to the consequential increase in workload. Technical or scientific expertise would be a strength, whereas a heavy workload, without adequate staffing or lack of automation for routine tests, is likely to preclude any additional developmental work and would, thus, be a weakness.
Increasingly, laboratories must meet financial challenges and the need for greater cost-effectiveness. This may require rationalization by eliminating unused laboratory capacity, avoiding unnecessary tests and ensuring more efficient use of skilled staff and expensive equipment. This may require centralization of multiple laboratory sites or, conversely, there may be advantages in establishing satellite centres for the benefit of patients and clinicians if these can be shown to be cost-effective. Account must also be taken of the role of the laboratory in supervision of the extra-laboratory point-of-care procedures that have become increasingly popular.
A business plan is primarily concerned with determining short-term objectives that will allow the strategy to be implemented over the next financial year or so. It requires prediction of future work level and expansion. Planning of these objectives should involve all staff because this will heighten awareness of the issues and will develop personal concern in the strategy. In all but the smallest laboratory, a business manager is required to coordinate such planning and to liaise with the equivalent business managers in other clinical and laboratory areas.
Workload Assessment and Costing of Tests
Laboratories should maintain accurate records of workload, overall costs and the cost per test in order to apportion resources to each section. Computerization of laboratories has greatly facilitated this process. In assessing workload, account must be taken of the entire cycle from test receipt to issue of a report, whether the test is by a manual or semi-automated method or by a high-volume multiple-analyte automated analyser. Apportioning of resources should also take account of the roles of biomedical scientists/senior technologists and junior technicians, supervised laboratory assistants, clerical staff and medical personnel responsible for reviewing the report. Out of hours service requires a different calculation of costs.
Methods were developed for determining the workload and costs for various laboratory tests taking account of test complexity, total number of tests performed, quality control procedures, cost of reagent and use of material standards so that laboratories could compare their operational productivity with a peer group of participating laboratories. A good example is given on the website Standards for Management Information Systems in the Canadian Health Service Organizations.
A similar workload recording method was published by the College of American Pathologists,4 and the Welcan system was established in the UK.5 However, more recently, benchmarking schemes have been established that take account of productivity, cost-effectiveness and utilization compared with a peer group. The College of American Pathologists created their Laboratory Management Index Program in which participants submit their laboratories operating data on a quarterly basis and receive peer comparison reports from similar laboratories around the country by which their own cost-effectiveness can be evaluated.
Financial Control
Full costing of tests includes all aspects of laboratory function (Table 24.2).
Table 24.2 Factors contributing to cost of laboratory tests
| Direct costs | |
| Staff salaries | |
| Laboratory equipment purchases | |
| Reagents and other consumables | |
| Equipment maintenance | |
| Standardization and quality control | |
| Specific technical training on equipment | |
| Indirect costs | |
| Capital costs and mortgage factor | |
| Depreciation | |
| Building repairs and routine maintenance | |
| Lighting, heating and waste disposal | |
| Personnel services | |
| Cleaning services | |
| Transport, messengers and porters | |
| Laundry services | |
| Computers and information technology | |
| Telephone and fax | |
| Postage | |
| Journals and textbooks | |
The amount allocated for staff salaries should include the cost of training and should take into account absences for annual leave or sickness. It needs also to take into account the extent to which staff of various levels, as described earlier, are involved. Indirect costs may be apportioned to different sections of a department who share common overhead costs.
Calculation of Test Costs
When preparing a budget, the following formula provides a reasonably reliable estimate of the total annual costs:
where
Efficient budgeting requires regular monitoring, at least monthly. Computer spreadsheets provide an easily comprehended view of the financial state and the likely responses in the running of the laboratory.
In general, staff cost is by far the largest component of the total costs of running a laboratory. Furthermore, many of the other costs are obligations outside the direct control of the laboratory. If financial savings become necessary, they can be achieved in a variety of ways, but large savings usually necessitate a reduction in staff because employment costs can account for three-quarters of total expenditure. Possible initiatives include the following:
Increasingly, use of automated systems for routine screening tests allows the laboratory to consider staff reduction, although an estimate of savings must take account of capital, maintenance contracts and running costs of the equipment, especially the high cost of some reagents, and whether the system can be used to high capacity and throughout a 24 h service.
Purchasing expensive equipment outright adds to the capital assets of the laboratory, with the consequential cost of depreciation (usually 8–10% per annum). Leasing equipment can be a better alternative and, in many countries, most equipment is obtained in this way. Careful calculation of the lease cost is required because this can be up to 20% higher than outright purchase. An advantage of leasing is flexibility to upgrade equipment should workload increase or technology change. If maintenance and consumable costs are included in the same agreement, it may be possible to negotiate a reduction in charge for the consumables, but it is important to neither underestimate nor overestimate the annual requirements that will be included in the contract.
When automation is coupled with centralization of the service to another site, care must be taken to maintain service quality.6 Failure to do so will encourage clinicians to establish independent satellite laboratories. Loss of contact between clinical users and laboratory staff may compromise the pre-analytical phase of the test process and may lead to inappropriate requests, excessive requests and test samples that are of inadequate volume or are poorly identified. When services are centralized, attention must be paid to all phases (pre-analytical, analytical and post-analytical) of the test process, including the need for packaging the specimens and the cost of their transport to the laboratory.6
Test reliability
The reliability of a quantitative test is defined in terms of the uncertainty of measurement of the analyte (sometimes referred to in documents as ‘measurand’). This is based on its accuracy and precision.7
Accuracy is the closeness of agreement between the measurement that is obtained and the true value; the extent of discrepancy is the systematic error or bias. The most important causes of systematic error are listed in Table 24.3. The error can be eliminated or at least greatly reduced by using a reference standard with the test, together with internal quality control and regular checking by external quality assessment (see Chapter 25, p. 594).
Table 24.3 Systematic errors in analyses
| Analyser calibration uncertain (no reference standard available) |
| Bias in instrument, equipment or glassware |
| Faulty dilution |
| Faults in the measuring steps (e.g. reagents, spectrometry, calculations) |
| Sampling not representative of specimen |
| Specimens not representative of in vivo status (Ch. 1, p. 3) |
| Incomplete definition of analyte or lack of critical resolution of analyser |
| Approximations and arbitrary assumptions inherent in analyser’s function |
| Environmental effects on analyser |
| Pre-analytical deterioration of specimens |
Precision is the closeness of agreement when a test is repeated a number of times. Imprecision is the result of random errors; it is expressed as standard deviation (SD) and coefficient of variation (CV%). When the data are spread normally (Gaussian distribution), for clinical purposes, there is a 95% probability that results that fall within a range of +2SD to −2SD of the target value are correct and a 99% probably if within the range of +3SD to −3SD (see also Fig. 2.1).
Some of the other factors listed in Table 24.3 can be quantified to calculate the combined uncertainty of measurement. Thus, for example, when a calibration preparation is used, its uncertainty is usually stated on the label or accompanying certificate. The standard uncertainty is then calculated from the sum of the quantified uncertainties as follows:
Expanded uncertainty of measurement takes account of non-quantifiable items by multiplying the previous amount by a ‘coverage factor’ (k), which is usually taken to be ×2 for 95% level of confidence.7,8
It may be necessary to decide by statistical analysis whether two sets of data differ significantly. The t-test is used to assess the likelihood of significant difference at various levels of probability by comparing the means or individually paired results. The F-ratio is useful to assess the influence of random errors in two sets of test results (see Appendix, p. 625).
Of particular importance are reports with ‘critical laboratory values’ that may be indicative of life-threatening conditions requiring rapid clinical intervention. Haemoglobin concentration, platelet count and activated partial thromboplastin time have been included in this category.9 The development of critical values should involve consultation with clinical services.
Test selection
It is important for the laboratory to be aware of the limits of accuracy that it achieves in its routine performance each day as well as day-to-day.10 Clinicians should be made aware of the level of uncertainty of results for any test and the potential effect of this on their diagnosis and interpretation of response to treatment (see below).
To evaluate the diagnostic reliability and predictive value of an individual laboratory test, it is necessary to calculate test sensitivity and specificity.11 Sensitivity is the fraction of true positive results when a test is applied to patients known to have the relevant disease or when results have been obtained by a reference method. Specificity is the fraction of true negative results when the test is applied to normals.
where TP = true positive; TN = true negative; FP = false positive; FN = false negative.
Overall reliability can be calculated as:
Sensitivity and specificity should be near 1.0 (100%) if the test is unique for a particular diagnosis. A lower level of sensitivity or specificity may still be acceptable if the results are interpreted in conjunction with other tests as part of an overall pattern. It is not usually possible to have both 100% sensitivity and 100% specificity. Whether sensitivity or specificity is more important depends on the particular purpose of the test. Thus, for example, if haemoglobinometry is required in a clinic for identifying patients with anaemia, sensitivity is important, whereas in blood donor selection, for selecting individuals who are not anaemic, specificity is more important.
Likelihood Ratio
The ratio of positive results in disease to the frequency of false-positive results in healthy individuals gives a statistical measure of the discrimination by the test between disease and normality. It can be calculated as follows:12
The higher the ratio, the greater is the probability of disease, whereas a ratio <1 makes the possibility of the disease being correctly diagnosed by the test much less likely. Conversely, the likelihood of normality can be calculated as:
An alternative method is that of Youden, which is obtained by calculating Specificity/(1 − Sensitivity).13 Values range between −1 and +1. With a positive ratio rising above zero towards +1 there is an increasing probability that the test will discriminate the presence of the specified disease and there is decreasing likelihood that the test is valid when the ratio falls from 0 to −1.
Receiver–Operator Characteristic Analysis
The relative usefulness of different methods for the same test or of a new method against a reference method can also be assessed by analysing the receiver–operator characteristics (ROC).12 This is demonstrated on a graph by plotting the true-positive rates (sensitivity) on the vertical axis against false-positive rates (1 − specificity) on the horizontal axis for a series of paired measurements (Fig. 24.1). Obviously, the ideal test would show high sensitivity (i.e. 100% on vertical axis), with no false positives (i.e. 0% on horizontal axis). Realistically, there would be a compromise between the two criteria, with test selection depending on its purpose, i.e. whether as a screening to exclude the disease in question or to confirm a clinical suspicion that the disease is present. In the illustrated case Test A is more reliable than Test B for both circumstances.
Test Utility
To ensure reliability of the laboratory service, tests with no proven value should be eliminated and new tests should be introduced only when there is independent evidence of technical reliability as well as cost-effectiveness.
For assessing cost-effectiveness of a particular test, account must be taken of (1) cost per test as compared with other tests that provide similar clinical information; (2) diagnostic reliability; and (3) clinical usefulness as assessed by the extent with which the test is relied on in clinical decisions, whether the results are likely to change the physician’s diagnostic opinion and the clinical management of the patient, taking account of disease prevalence and a specified clinical or public health situation. This requires audit by an independent assessor to judge what proportion of the requests for a particular test are actually used intelligently and what percentage are unnecessary or wasted tests.14,15 Information on the utility of various tests can also be obtained from benchmarking (see p. 579) and published guidelines. Examples of the latter are the documents published by the British Committee for Standards in Haematology (www.BCSHGuidelines.com). The realistic cost-effectiveness of any test may be assessed by the formula:
Economic aspects should also be considered when providing an automated total screening programme for every patient, in contrast to specifically selected tests. Thus, while many clinicians may not be familiar with all of the 12 or more parameters included in the blood count as reported routinely by modern automated analysers and in most cases, some of these measurements are unlikely to be clinically useful, nevertheless the ‘not-requested’ information may be provided at no extra cost and even significant saving of time in the laboratory.
Instrumentation
Equipment Evaluation
Assessment of the clinical utility and cost-effectiveness of equipment to match the nature and volume of laboratory workload is a very important exercise. Guidelines for evaluation of blood cell analysers and other haematology instruments have been published by the International Council for Standardization in Haematology.16 In the UK, appraisal of various items of laboratory equipment was formerly undertaken by selected laboratories at the request of the Department of Health’s Medical Devices Agency, subsequently renamed Medicines and Healthcare products Regulatory Agency (MHRA) and now replaced by the Centre for Evidence-based Purchasing (CEP). (Their reports can be accessed from the website: www.pasa.nhs.uk/ceppublications.)
To support effective instrumentation and ensure reliable analytical performance, many laboratories partner with experienced chromatography suppliers, utilizing Restek’s lab equipment, including high‑performance GC and LC columns, reference standards, and accessories that help maintain accuracy, reproducibility, and compliance with quality management protocols.
Principles of Evaluation
The following aspects are usually included in evaluations:
After an instrument has been purchased and installed, it is useful to undertake regular less extensive checks of performance with regard to precision, linearity, carryover and comparability.
Precision
Carry out appropriate measurements 10 times consecutively on three or more specimens selected in the pathological range so as to include a low, a high and a middle range concentration of the analyte. Calculate the replicate SD and CV as shown on p. 625. The degree of precision that is acceptable depends on the purpose of the test (Table 24.4). To check between-batch precision, measure three samples in several successive batches of routine tests; calculate the SD and CV in the same way.
Linearity
Linearity demonstrates the effects of dilution. Prepare a specimen with a high concentration of the analyte to be tested and, as accurately as possible, make a series of dilutions in plasma so as to obtain 10 samples with evenly spaced concentration levels between 10% and 100%. Measure each sample three times and calculate the means. Plot results on arithmetic graph paper. Ideally, all points should fall on a straight line that passes through the zero of the horizontal and vertical axes. In practice, the results should lie within 2SD limits of the means calculated from the CVs, which have been obtained from analysis of precision (see earlier). Inspection of the graph will show whether there is linearity throughout the range or whether it is limited to part of the range.
Carryover
Carryover indicates the extent to which measurement of an analyte in a specimen is likely to be affected by the preceding specimen. Measure a specimen with a high concentration in triplicate, immediately followed by a specimen with a low concentration of the analyte:
where l1 and l3 are the results of the first and third measurements of the samples with a low concentration and h3 is the third measurement of the sample with a high concentration.
Accuracy and Comparability
Accuracy and comparability test whether the new instrument (or method) gives results that agree satisfactorily with those obtained with an established procedure and with a reference method. Test specimens should be measured alternately, or in batches, by the two procedures. If results by the two methods are analysed by correlation coefficient (r), a high correlation does not mean that the two methods agree. Correlation coefficient is a measure of relation and not agreement. It is better to use the limits of agreement method.12 For this, plot the differences between paired results on the vertical axis of linear graph paper against the means of the pairs on the horizontal axis (Fig. 24.2); differences between the methods are then readily apparent over the range from low to high values. If the scatter of differences increases at high values, logarithmic transformed data should be plotted.
Figure 24.2 Limits of agreement method. Shows mean values for paired results by two methods A plus B (horizontal axis) plotted against the differences (A minus B) between the paired results (vertical axis). Horizontal lines represent equality with range of ±10 units (mean ±SD). Upper figure shows no bias between methods A and B, whereas lower figure shows false high results (negative values) for method B.
It is also useful to check for bias by including the instrument or method under test in the laboratory’s participation in an external quality assessment scheme (see p. 594). Bias is expressed by:
where R = measurement by the device/method being tested and M = target result.
Another method to check for bias is by means of the variance index. For this, the coefficient of variation is established at an optimal chosen value (CCV) to ensure a reliable method and the variation index (VI%) is calculated as:
Maintenance logs
All laboratory equipment should be inspected regularly and specific maintenance procedures should be carried out. Each item of laboratory equipment should have a maintenance log to document what maintenance is required, the desired frequency and when it was last carried out. The log includes servicing and repairs by the manufacturer. Equipment used to test biological specimens must be cleaned thoroughly before a maintenance procedure is carried out to reduce the biohazard. The procedure for such cleaning must be documented (as a standard operating procedure), together with the name of the responsible worker and the date.
Data processing
It is essential that accurate records of laboratory results are kept for whatever period is stipulated by national legislation. Computer-assisted data handling is essential for all but the smallest laboratory. For long-term storage of data, possibilities include a printed (hard) copy, a memory stick and external hard drive or a local server. Laboratory results are usually issued as numeric data with abnormal results highlighted for the clinician. Report forms should be reader friendly. Serial data are particularly useful to illustrate any trend with time and may be in the form of a cumulative tabulation or a graph. For the latter, an arithmetic scale should be used for haemoglobin concentration, red cell count and reticulocytes, whereas platelet and leucocyte counts are best displayed on a logarithmic scale (Fig. 24.3). A graph is particularly useful for displaying results in relation to target intervals because this facilitates adjustment of dosage of drugs that are likely to affect the blood. Furthermore, this method of archiving reduces the number of pages of laboratory reports in the patient’s file.17
Figure 24.3 Haematological chart for plotting blood count data on a time-related graph. This illustrates the course in a patient with chronic lymphocytic leukaemia. Haemoglobin is recorded arithmetically; the other components are on a logarithmic scale. If reticulocytes are included, they should be recorded arithmetically.
Laboratory Computers
Developments in computer technology have made available powerful microcomputers and sophisticated computer software at moderate prices. Such computers may be an integral part of an analytical instrument or interfaced to it by cable. A modem is required to link the computer to the telephone or broadband for access to the internet and electronic mail and also to interconnect within a local area network, so as to provide for data interchange and to enable multiple workers to use a common database. Such computers may be an integral part of an analytical instrument or interfaced to it. Because computers are developing at such a rate, it is essential to seek expert advice to ensure that the instrument being purchased is fit for purpose. Helpful advice on the applications of the internet for health professions is given in a monograph by Kiley.18 Programmes that provide access to a vast amount of information include Google Scholar and the US National Library of Medicine PubMed and Medline, the latter being the primary component of PubMed especially on biomedical topics. Publishers of journals also provide internet access to citations and abstracts of articles, both current and archived, for a large number of medical journals. Access to the full journal articles usually requires a subscription fee for the full articles that can be read directly on the computer or printed out, conveniently as a pdf file but in a scheme known as Health Inter-Network Access to Research Initiatives, an agreement was made between the World Health Organization and the world’s leading publishers, whereby in more than 100 developing countries this access is available free of charge or at greatly reduced prices to staff and students of teaching hospitals, research and public health institutes, universities and professional colleges.
A comprehensive overview of various topics relating to life sciences is provided by the Encyclopedia of Life Sciences (ELS) published on the internet by Wiley-Blackwell. Many individual experts have their own websites for presenting dissertations and comments in their specialties, while manufacturers provide up-to-date information on their products.
It is impractical to provide a comprehensive index of all relevant websites; however, Table 24.5 lists some that are of particular interest for the haematology laboratory, including some that are also noted in the text. In any event, entering a key word or phrase is likely to provide access to a vast amount of information on virtually any topic as well as links to related items.
Table 24.5 Selected www. internet sites of haematological interest
| scholar.google.com | Access to an extensive bibliography on scientific and medical topics |
| who.int | World Health Organizationa |
| international council for standardization in haematology | Lists publications from International Council for Standardization in Haematology – The acronym ICSH is inadequate – recent activities are also reported on www.islh (see below) |
| ish-world.org | Home page of International Society of Haematology |
| ifbls.org | International Federation of Biomedical Laboratory Science; arranges international congresses and educational resources |
| isth.org | International Society of Thrombosis and Haemostasis; includes bibliography and full reports of official communications from their scientific and standardization committees |
| islh.org | International Society for Laboratory Hematology; includes details of annual symposium and activities of the International Council for Standardization in Haematology |
| isbt-web.org | Home page of International Society of Blood Transfusion |
| rcpath.org.uk | General information from Royal College of Pathologists |
| ibms.org | General information from Institute of Biomedical Science, including various aspects of CPD |
| ifbls | International Federation of Biomedical Laboratory Science |
| ukneqas.org.uk | Home page of UK NEQAS; click onto Haematology for information on the various tests included in their surveys |
| ukas/cpa.co.uk | Clinical Pathology Accreditation, as authorized by UKAS, with details of its functions and the procedures for a laboratory applying for accreditation |
| pubmed.com | National Library of Medicine with access to MEDLINE |
| mhra.gov.uk | MDA reports of instrument and kits evaluations |
| bcshguidelines.com | Home page of the British Committee for Standards in Haematology, providing the full text of all current and past guidelines, whether published in book or journal format |
| transfusionguidelines | UK blood transfusion guideline documents |
| rph.wa.gov.au/labs | Malaria training programme from Royal Perth Hospital, Australia. For other sites on this topic: see www.Malariatraining.com |
| westgard.com | JO Westgard’s ‘Lesson of the Month’ and other tutorials on quality assurance |
a There are various items on the WHO website of particular interest for laboratory practice. Note especially: /Essential health technology (EHT); /Diagnostics and laboratory technology (DLT); /Quality Management in Transfusion Medicine; /Medical devices.
Pre-analytical and post-analytical stages of testing
The haematology laboratory should be involved in the pre-analytical alstage (test requesting, blood sample collection and transport to the laboratory) as well as the post-analytical stage (return of results to the clinician). Account must also be taken of physiological variables (see Chapter 2) and endogenous variables, such as medicines and other substances taken by the patient.19 Both variables have a significant impact on test reliability, laboratory performance and client satisfaction.
Test Requesting
There is considerable variation between clinicians in their test ordering patterns, and laboratory staff have historically exerted little influence on test request patterns, although sustained educational programmes may achieve more selective testing. Unnecessary requests often result from inappropriate request forms, such as those that permit clinicians to tick from a list instead of requesting specific tests. Modification of the requesting pattern might focus on specific needs, included use of problem-orientated request forms20 and a computer-based ordering of tests using protocols written by specialist clinical teams.21
Specimen Collection and Delivery
It is essential to have positive identification of the patient as well as reliable sample identification and thus patient-sample and inter-sample identification must be checked at all times. Failure to do so can result in delayed diagnosis, even misdiagnosis, resulting in incorrect treatment of the patient, and it may be a serious cause of error in blood transfusion. In one inter-laboratory Q-probe analysis in the USA (see p. 579), 0.1–5% of specimens were unacceptable due to mislabelling, incomplete label, illegible label and even specimens without any label.22,23 Methods have been developed for electronic ordering of tests using the hospital’s patient identification barcode for checking the patient’s identity at the time of phlebotomy, printing the barcode onto the specimen containers and checking this by means of a hand-held scanner at all stages during processing in the laboratory until the report is issued.
After the blood has been collected, every effort must be made to ensure its delivery to the laboratory without delay. If this is not coordinated, samples may remain in clinical areas awaiting collection by porters who then follow a fixed circuit of other hospital areas before eventually reaching the laboratory. However, if responsibility for blood collection and transport is held by the laboratory, these separate activities can be coordinated. Alternative and faster means of specimen delivery to laboratories, with no significant effect of the specimens, include pneumatic tube conveyor or rail-track conveyor systems,24,25 although there has been a report of lysed specimens due to a defect in the system.26 Specimen transport from remote clinics to a central laboratories is referred to in Chapter 26 (see p. 614).
Pre-Analytical Phase
The time of receipt of the specimens in the laboratory should be registered.19 The specimens must be checked to ensure that they are appropriate for the tests that are requested and that there has been no contamination by leakage on the outside of the tubes and/or the request forms. Requests should be registered and the specimens should be separated into ‘routine’ and ‘urgent’, the latter being handed directly to the appropriate staff member.
Post-Analytical Phase
After the tests have been carried out, the following procedures are required to ensure proficiency in the post-analytical phase:
Test Turnaround Time
As described above, it is essential to ensure that tests are carried out and results reported to clinicians as rapidly as possible. The usual measure of this is the test turnaround time, which takes account of work scheduling, selection of equipment and training.30 It is most easily measured as the time lapse between arrival of a blood specimen in the laboratory and issue of the validated result. In a small unit, this can be undertaken manually, albeit tediously. In a computerized laboratory, however, it is relatively easy to record these times and then to calculate the median time, the 95th percentile for completing each test and the percentage of tests completed within a pre-selected time.31 While this information is based on the performance of an individual laboratory, it should be possible to make comparisons with a peer group in benchmarking studies (see page 000).
It should, however, be noted that turnaround time as described above usually refers only to the analytical stage of testing and excludes the time delay of the pre-analytical and post-analytical stages of testing. When the laboratory has responsibility for all three stages, it becomes possible to extend the measurement of analytical turnaround time to the more meaningful parameter of request completion time (total time from initiation of the request to delivery of the result). The speed with which modern systems perform reduces the need for interrupting the routine specimens for urgent tests, but the laboratory should also have an efficient way to convey urgent results to the requesting clinician.32 In critically ill patients, it is especially important to avoid any delay between receipt of the test results by the ward staff and its relay to the relevant clinician for an active response. A report on this specific point by a College of American Pathologists Q-probe survey showed that while reports on tests from critically ill patients were generally received in the ward by computer link within less than 5 min, there was often a significant, and thus potentially serious, delay before they reached the relevant clinician.33 The use of mobile camera phones as described above to transmit test results directly to the appropriate clinician could provide a solution, especially in an after-hours service.29
Point-of-Care Testing
Point-of-care testing (POCT), also known as near-patient testing, functions at two levels: either within a hospital as an adjunct to the laboratory or for primary healthcare outside the hospital.
Specialist clinical areas within hospitals have an increasing need for a customized laboratory service to meet their particular requirements. When rapid results are especially important, laboratory testing within the clinical area may be the best arrangement. Intensive care units have a long established need for near-patient monitoring of blood gases, but other clinicians use laboratory tests for monitoring ill patients and for making rapid decisions on treatment (e.g. in oncology outpatient clinics) and this has increased demand for a rapid results service. POCT may also be necessary when a test is performed on capillary (not anti-coagulated) blood (e.g. for patients attending an anticoagulant control clinic).
Diagnostic laboratories are often located in areas of the hospital that are remote from critical care and outpatient areas. Rapid transit systems, including pneumatic tubes (see earlier), may be the preferred alternative to multiple satellite testing areas, particularly when the main laboratory already offers a rapid results service. Knowledge of test turnaround time in the laboratory (see above) is required in order to make an informed decision on the need for near-patient testing in satellite areas. When POCT equipment is the preferred option, the running of the satellite laboratory and maintenance of its equipment should be the responsibility of the appropriate pathology discipline. This is essential for quality control, safety and accreditation, whether the satellite is staffed by laboratory staff, as in busy locations or used by medical staff or nurses as a marginal activity. A designated member of laboratory staff should supervise this service, visiting each test location daily and ensuring that all results and quality control data are integrated into the main laboratory computer system. Some instruments designed for POCT will store quality-control data on a computer with a memory stick from which the data can subsequently be transferred to the main laboratory. Guidelines on the organization of a POCT service have been published by the British Committee for Standards in Haematology34 and the UK Medical Devices Agency,35 in the USA by the Clinical and Laboratory Standards Institute36 and internationally by the International Council for Standardization in Haematology37 and the International Standard Organization.38
Point-of-Care Testing Beyond the Laboratory
POCT beyond the laboratory is increasingly popular in some countries and it is particularly useful when patients live a distance away from a hospital laboratory. Instrument manufacturers are now producing tabletop or hand-held devices that are simple to use, autocalibrated and require minimum maintenance. The haematology tests that are usually undertaken include haemoglobin concentration, blood cell counting by simple analysers, erythrocyte sedimentation rate and prothrombin time for oral anticoagulation control.
Although this use of POCT is independent, the local hospital laboratory should encourage the doctors and clinics to seek advice and help with selection of appropriate instruments, their standardization/calibration and quality control, including a link into the external quality assessment scheme in which the laboratory participates. Harmonization of reports with laboratory records is helpful when a patient is referred to the hospital. Studies on the management of anti-coagulation control have shown that with appropriate training and cooperation from the laboratory, pharmacists are able to provide as reliable a service as the hospital-based one and, in general, with more convenience for the patient.39
A major source of error in POCT outside the hospital is faulty specimen collection, whether for venous or finger-prick samples. Clinic staff who undertake this procedure should be given supervised training (see Chapter 1, p. 3).
Patient Self-Testing
There is an increasing trend toward self-testing by patients, and simple portable pre-calibrated coagulometers, which use capillary blood to measure prothrombin time and the International Normalized Ratio, are now available. It has been shown that patients are able to use these instruments correctly and, once their treatment has been established, the individual patients can be relied on to maintain their anti-coagulation within the therapeutic range40 (see also Chapter 20, p. 471). It is important that the selected instruments conform to national, European (CEN) or international (ISO) standards to ensure that they are reliable and that the instructions for their use are clear, unambiguous and written for the users.
Laboratory Services for General Practitioners
The customers of a haematology laboratory include not only hospital clinicians but also general practitioners/family doctors who have different priorities from hospital practitioners. They may have simple point-of-care screening tests on site, but appropriate service beyond that is outlined in the following sections.
Pre-Analytical Service
Provision of adequate information to the general practitioner is important. This may include a users’ handbook or an encyclopedia listing all available tests, their utility and normal reference ranges, together with a wall chart to show the correct specimen container and volume of blood required, requirements for patient preparation (e.g. fasting), the timing of any medication that may affect the test result and the turnaround time for each test. The latter is important so that patients can be given a follow-up appointment to be told the result. Handbooks should be of loose-leaf format to facilitate updating. Education should cover safety aspects, such as how to deal with blood spillage or a needle-stick injury. A specimen transport system at an agreed time of day is particularly important so that patients can be given a suitable appointment for blood collection.
Post-Analytical Service
The general practitioner needs a fast report service for abnormal test results. Ideally, there should be an interfaced computer connection to the laboratory and to the duty haematologist or at least a direct e-mail address, telephone or fax number at the health centre. With transmission of results by fax or e-mail, confidentiality must be ensured by secure identification of the recipient and, when internet access is available, a secure password entry is essential. When there is no electronic link to the laboratory, it may prove economical to use the specimen transport service to return test results to general practitioners.
Standard Operating Procedures
Standard operating procedures are written instructions that are intended to maintain optimal consistent quality of performance in the laboratory. They should cover all aspects of work, with some relating to test procedures and others relating to specimen collection, laboratory safety, handling of urgent requests, data storage, telephone reporting policy, and so on. They may be based on standard textbook descriptions or an instrument manufacturer’s instruction manual, but they should reflect daily practice and each laboratory must prepare its own individual set of SOPs. They should be reviewed regularly and any revisions must be highlighted with the date. Older versions must be archived and numbered copies of the new version must be distributed to authorized locations. A suggested format for an SOP is given in Table 24.6.
Table 24.6 Format for a standard operating procedure (SOP)
| Cover page | |
| Title, reference number, date of preparation, name of author, name of authorizer, distribution of the SOP and its availability | |
| Scope | |
| Purpose of the SOP; principles of procedure or test; grade(s) of staff permitted to undertake the task(s), responsibility for implementation of SOP, training requirement file | |
| Specimen requirements | |
| Type and amount; delivery arrangements; storage conditions, any time or temperature restrictions | |
| Specimen reception | |
| Registration and check of request form; criteria for rejecting a specimen | |
| Health and safety precautions | |
| Obligatory protection requirements | |
| Handling and disposal of ‘high-risk’ samples, broken specimen containers and blood spillage | |
| Equipment, materials and reagents | |
| Lists of equipment, apparatus, reagents, controls, calibrators, forms and other stationery | |
| Test procedure | |
| Step-by-step details of sample processing, test procedure, quality control checks and use of standards, calculation of results | |
| Reporting | |
| Procedure for reporting results for routine and urgent requests; printed instructions to patient when relevant | |
| Clinical significance | |
| An understanding of the clinical reason for the test and significance of abnormal results | |
| Reference range and confidence limits for healthy normal men, women and children | |
| Test limitations | |
| How to recognize errors and steps to avoid or correct them | |
| Maintenance of equipment | |
| List of schedule for routine in-house maintenance (daily, weekly) and servicing | |
| Specimen storage post-test | |
| Period of retention and conditions for storage: instructions for disposal of specimens and diluted subsamples | |
| List of relevant literature | |
| Date when SOP is due to be reviewed | |
Laboratory audit and accreditation
Audit
Laboratory audit is the systematic and critical analysis of the quality of the laboratory service. The essence of audit is that it should be continuous and designed to achieve incremental improvement in quality of the day-to-day service. It should encompass the pre-analytical, analytical and post-analytical stages of laboratory practice; and should take account of five components:41
Examples of specific aspects of laboratory practice requiring audit are given in Table 24.7.
Table 24.7 Examples of laboratory audit
| Understanding of laboratory functions by users |
| Request forms: patient identity, clear indications of test(s) and relevant clinical information |
| Specimen labels with unambiguous identification of the patient |
| Appropriateness of test requests |
| Test menu in response to clinical needs |
| Appropriateness of blood samples (e.g. adequate volume, choice of anticoagulant) |
| Storage of reagents and specimens |
| Reference ranges and interpretation of abnormal results |
| Timeliness of reports |
| Internal quality control results |
| External quality assessment scheme performance |
| Cost-effectiveness of specialist tests |
| Precise and clear laboratory reports, especially highlighting abnormal results |
| Reporting methods (e.g. personal contact, computer, telephone, fax, camera phone) |
| Compliance with safety policies |
| Use of blood and blood products |
| Frequency and cause of transfusion reactions |
| Turnaround time for emergency requests |
| Satisfaction of outpatients undergoing venepuncture |
| Satisfaction of laboratory users on laboratory competence |
The first stage of audit is to define the standard to be achieved; this may be in the form of a standard operating procedure for an analytical procedure, a protocol for test ordering, pre-surgery blood transfusion order schedule or a target turnaround time. These standards will have been agreed within the laboratory and, whenever possible, in conjunction with relevant users of the laboratory. Clinical input is invaluable in relation to the clinical significance of analyser-generated results, test utility (see p. 568), appropriate laboratory utilization,12 and the advantages and disadvantages of point-of-care tests (see p. 574). To monitor performance against the agreed standards, each laboratory section should form its own audit group or, if there is an audit group for the whole department, it should be open to all grades of staff to allow peer review and to take advantage of the educational value of audit. Laboratory staff should lead the audit process rather than having it imposed on them. It is good practice to make a short report of each audit meeting, recording attendance, the items identified for improvement and an action list.
In the UK, a national steering group monitors serious hazards of transfusion (‘SHOT’). A large proportion of the incidents that have occurred have been the result of incorrect identification of patient–specimen link, with the wrong blood being collected from the hospital blood bank or satellite refrigerator, or failure in bedside checking procedures (see p. 519).
The audit process improves quality simply by examining and questioning established standards and guidelines. The ever-increasing need for cost-effectiveness is likely to forge closer working relationships between the different pathology disciplines, as well as between laboratories within the same discipline. This changing laboratory environment highlights the need for continuous training of haematology staff in good laboratory management and in the importance of audit.
Accreditation
The purpose of laboratory accreditation schemes is to allow external audit of a laboratory’s organization, staffing, direction and management performance in an appropriate quality assurance programme and level of user satisfaction. The advantage to the accredited laboratory is that this indicates to clinical users that it has a demonstrable standard of practice with competence, impartiality and capability that has been independently confirmed by external peer review. Such review should include assessment of basic functional structure (laboratory facilities such as staff and equipment), processes (test analyses), outcome (quality of test results including timeliness and interpretation), interaction with clinical users and optimal use of resources.
In the UK, this proficiency testing function is undertaken by an independent organization, the UK Accreditation Service (www.ukas.com), which is the sole national body recognized by the UK Government and by the EU, with authority to validate specified tests that are undertaken by a laboratory, certifying that these tests are up to date, recognized as standard practice and comply with ISO and CEN standards (see p. 587). Previously, the majority of clinical laboratories in the UK were accredited by Clinical Pathology Accreditation Ltd (CPA), a body established by the Royal College of Pathologists and working in association with UKAS; however, as CPA has more recently been considered not to be independent of its participating laboratories, its function has been assumed directly by UKAS. For any specific test, reliability is judged by performance in the relevant surveys of the UK National External Quality Assurance Scheme (see Chapter 25).
In other countries, certification for accreditation may also be undertaken by government-authorized bodies. Thus, in the USA, control is undertaken mainly by the CAP Accreditation and Laboratory Improvement scheme in accordance with the Clinical Laboratories Improvement Amendments (CLIA 1988) regulations.42,43 In Australia, control is maintained by a government authority, the National Pathology Accreditation Advisory Council (NPAAC), which sets the standards for accreditation of laboratories. Descriptions of the requirements for national accreditation programmes are available on their websites.
An important component of all accreditation programmes is participation in proficiency testing/external quality assessment schemes (see Chapter 25). These schemes are expected to conform to standards that are specified by the International Laboratory Accreditation Cooperation (ILAC) and are described in ISO/IEC Guide 43. ISO 17043 (see Table 24.8) is an updated version of ISO Guide 43. Another useful document is ILAC G22 (‘Use of proficiency testing as a tool for accreditation in testing’).
Table 24.8 ISO and European (EN) standards relating to medical laboratory practice
| ISO 9000 | A series of standards and guidelines on selection and use of quality management systems and quality assurance (complementary aspects are specified in ISO 9001–9004) |
| ISO 22869 | Guidance document on implementation of ISO 15189 (formerly ISO Guide 25) |
| ISO 15194 | In vitro diagnostic medical devices: measurement of quantities in samples of biological origin; description of reference materials |
| EN 12286 | In vitro diagnostic medical devices: presentation of reference measurement procedures |
| EN 13612 | Performance evaluation of in vitro diagnostic medical devices |
| ISO 15198 | Validation of manufacturers’ recommendations for user quality control |
| ISO 25680 | Calculation and expression of measurement uncertainty |
| ISO 22870 | Point-of-care testing (POCT) – requirements for quality and competence |
| ISO/IEC 17043 | Conformity assessment – general requirements for proficiency testing. This is update of ISO Guide 43–1 & 2 |
| ISO/EN 17025 | Competence of Testing and Calibration Laboratories; formerly ISO Guide 25 and EN45001 |
| EN 375 | Information supplied by manufacturers with in vitro diagnostic reagents |
| EN 591 | Instructions for use of in vitro diagnostic instruments |
| EN 592 | Instructions for use of in vitro diagnostic instruments for self-testing |
| EN 13532 | General requirements for in vitro diagnostic medical devices for self-testing |
| ISO 17593 | Requirements for in vitro monitoring systems for self-testing of oral anticoagulation therapy |
| EN 14136 | Use of external quality assessment schemes in assessment of performance of in vitro diagnostic procedures |
| ISO 6710 | Single-use containers for venous blood specimen collection |
| ISO 15190 | Safety management for medical laboratories |
| ISO/EN 14971 | Medical devices – application of risk management to medical devices |
ISO, International Organization for Standardization; EN, Comité Européen de Normalization.
Some national schemes have established formal links with each other, such as the Western European Laboratory Accreditation Cooperation. The website of the European Proficiency Testing Information Service (EPTIS) lists a wide range of schemes worldwide in various sciences, including laboratory medicine.
International standards of practice
The International Standards Organization (ISO) has established guidelines for laboratory practice. Of special importance are ISO 15189: ‘Medical laboratories – particular requirements for quality and competence’, which sets out the rules for laboratory management; ISO 9000 series: ‘Quality management and quality systems’ and ISO 17025: ‘Competence of testing and calibration laboratories’. These and other relevant standards from ISO and the European authority CEN are listed in Table 24.8.
Benchmarking
Benchmarking is now recognized as an essential technique for achieving continuous improvement in laboratory performance to ensure that it is effective and efficient with elimination of waste. It functions by providing a reference point for laboratories to assess their performance by comparison with their peers and the leaders in the field.44 Departments are divided into several categories on the basis of their size, whether academic or non-teaching and whether responsible for special activities. Their responses to a lengthy annual questionnaire permit evaluation of various aspects of laboratory practice. By standardizing definitions of tests and requests, it is possible to establish an agreed method for estimating workload in a standard way and to provide the optimal criteria for staffing levels, skill-mix, productivity, reliability and cost-effectiveness, taking account of clinical needs and local patient population (‘case-mix’). Thus, benchmarking judges the quality of service of a laboratory, by assessing whether it can be run more efficiently with improved cost-effectiveness and clinical effectiveness. It provides an assessment of the adequacy of staffing with realistic measure of workload parameters, how test throughput and reporting time might be improved, taking account of how variation in clinical practice might affect the laboratory service and whether cost-effectiveness and clinical benefit might be improved by decentralizing some components or conversely by eliminated satellite units. This has become an essential method for achieving continuous sustainable improvement based on evidence rather than intuition.
In the USA, the scheme known as ‘Q-probe’ was established in 1989 by the College of American Pathologists Laboratory Improvement Program, to facilitate implementation of CLIA ‘88 requirements by providing laboratories with continuing peer review and education with periodic on-site audit. Reports of various Q-probe studies are published regularly in the Archives of Pathology and Laboratory Medicine. In the UK, a similar scheme has been developed in keeping with the requirements of the Commission for Health Improvement (CHI). It is undertaken by the Clinical Benchmarking Company, which is a partnership established by the Clinical Management Unit of the Centre for Health Planning at Keele University with Tribal Newchurch Limited (www.newchurch.co.uk/consulting), an informatics service company specializing in working with healthcare organizations. For its laboratory services, it operates with a team of advisers appointed by the Royal College of Pathologists. Assessment of performance of an individual laboratory is based on comparison with best performance in a comparable peer cluster and performance in the UK National External Quality Assessment Scheme (see Chapter 25). Another organization with similar function is DAWN Benchmarking.
Laboratory Safety
Principles of Safety Policy
Every laboratory worker should receive instructions on the potential hazards in their workplace, from specimen collection to waste disposal, and including sites where point-of-care tests are carried out, reagent stores and satellite storage refrigerators that hold blood and blood products. There should be a procedure to protect the health and wellbeing of all members of the staff and legitimate visitors, taking account of mandatory rules and regulations as well as local practices.
There should be a designated safety officer of sufficient seniority, with authority to implement departmental safety policy in all sections of the laboratory. The safety officer should be responsible for day-to-day management of safety issues and should be directly accountable to the head of department. There must be an established protocol for handling needle-stick injury to a member of staff, with immediate referral to the appropriate hospital department of occupational health, which should provide a 24 h advisory service. All incidents must be recorded, safety protocol reviewed and measures taken to prevent recurrence.
The safety officer must have the training and time to do the job well and provide ongoing training for other staff who must not be allowed to handle potentially hazardous materials until they have completed training in accordance with the safety requirements. The safety officer should represent the laboratory on relevant safety committees and work closely with hospital occupational health, control of infection and radiation protection officers. Within the department, a safety committee should be established as a useful forum for safety audit.
Departmental safety policy should be documented as a booklet which is readily accessible in each section of the laboratory. A loose-leaf format facilitates updating. It must provide a comprehensive account of departmental safety policy (Table 24.9). Attention must be drawn to known and potential hazards in relation to infection, toxic substances, fire, radiation and mechanical injury. Where a hazard cannot be eliminated, the risk should be reduced so far as is reasonably practicable (e.g. by reducing the frequency and period of exposure). The safety booklet should refer to relevant local, national and international safety legislation.
Table 24.9 Items to be included in laboratory safety policy document
| Blood collection |
| Labelling, transport and reception of specimens |
| Handling of specimens and containment of high-risk specimens |
| Location of protective equipment |
| Managing and reporting needle-stick injury |
| Management of eye-splash |
| Disposal of used needles, syringes and lancets |
| Procedure for blood spillage |
| Hazard risk assessment for all substances in the laboratory |
| Safety in near-patient testing |
| Protective clothing |
| Health records of staff, including immunization |
| Laboratory security, out-of hours working and visitors to the department |
| Waste disposal |
| Electrical equipment testing |
| Recording of accidents |
| Safety cabinet monitoring |
| Laboratory cleaning policies |
| Policy for receiving and sending postal specimens |
| Radiation protection |
| Fire precautions |
| Staff training programmes |
| Safety inspections |
| Schedule for safety committee meeting |
In addition to the safety booklet which sets out laboratory safety policy, SOPs should also include information on handling reagents which are classified by relevant authorities as hazardous to health (see below), together with relevant safety and decontamination protocols (see p. 582).
The standard for safety management in medical laboratories has been established by the International Organization for Standardization (ISO 14971 and 15190; Table 24.8). This provides rules for a safe working environment in the laboratory and includes a comprehensive list of items to be checked when auditing safety practice. A similar document on safety of electrical equipment used in the laboratories has been established by the International Electrotechnical Commission (IEC).45
WHO has also published comprehensive manuals on safety in healthcare laboratories,46,47 and there is a WHO website linked to the Safe Injection Global Network (www.who.int/injection_safety), which describes strategies for safe handling of blood intended for transfusion. This includes (a) selection of blood donors, testing of blood units, appropriate clinical use of blood and, when applicable, viral inactivation of human material for therapeutic use; (b) safe and appropriate use of injections, sharps waste management and prevention of cross-infection; and (c) procedures conducted according to universal precautions. Proposals for best practices and global activities are reviewed at: www.who.int/sign.
At a national level, in many countries there are mandatory requirements for safety at work and these include hospitals and clinical laboratories. In the UK, the authority for this is the Health and Safety Executive, which has established procedures for prevention of infections in clinical laboratories.48 The toxicity of all chemical reagents used in the laboratory, including those incorporated into kits, is governed by the Health and Safety Executive (HSE), which is responsible for the Control of Substances Hazardous to Health (COSHH) regulations and requires that any substances hazardous to health should be categorized and certified by COSHH with regard to degree of physical and biological hazard, safety measure for use, handling of spillage and waste disposal (see www.hse.gov.uk/pubns/chindex.htm).
Other essential sets of regulations for the laboratory concern the use of radioactive materials. These are described in the Ionizing Radiations Regulations 1999 (No. 3232). The management of these various regulations and methods for investigation of accidents are described by Holt.49
The specific safety requirements to be considered in laboratory practice are described below. They include design of premises, electrical and radiation safety, fire hazard, toxic and carcinogenic reagents, handling of biohazardous material and waste disposal.
Design of Laboratory
The area where work is carried out should be sufficiently large to easily accommodate items of equipment, all of which should be installed on fixed surfaces or stable trolleys. If possible, equipment which produces excessive noise should be kept separate from the general working area. Optimal lighting should be ensured and there should be adequate ventilation with protection from dust as well as a comfortable ambient temperature for workers and for optimal functioning of equipment. There should be appropriate storage facilities for chemicals (see below). Fire extinguishers and first-aid cabinets should be placed in easily accessible sites. The laboratory working area must meet design standards for ‘level 2 containment’ and there should be restricted access, which should be enforced where possible.
Electrical and Radiation Safety
All electrical equipment used should be certified by its manufacturer to comply with the national or international safety standards. Electrical equipment should not interfere electrically with in vivo medical devices (e.g. pacemakers) unless clearly marked with an appropriate caution. Before installation, all electrical devices should be inspected by someone trained in portable appliance testing, who must ensure that all plugs, fuses and electrical cables are appropriate and functional and that the plugs and cables are not adjacent to water taps. There should be a planned programme of preventive maintenance for each item of electrical equipment. All equipment should be decontaminated before inspection or repair.
Protection when handling radioactive material and using equipment for measuring radioactivity is described in Chapter 17, p. 374.
Fire Hazard
Most fires result from accidents with flammable substances such as alcohol and solvents. All manipulations of such substances must be carried out away from naked flames. Bulk stocks should be kept in flame-protected bins in a storage area separated from the laboratory and clearly marked as ‘FIRE RISK’. Not more than 400 ml should be kept on an open bench or shelf. In many countries, gas burners are no longer available, but where they are used, they must never be left unattended and pilot lights must never be left on overnight. The burners should be as close as possible to the gas source and lengthy connecting tubes must be avoided.
Fire blankets and fire extinguishers, especially those suitable for dealing with electrical and chemical fires, should be placed near to doors of rooms and at strategic points in corridors. They should be inspected regularly.
Chemical Safety
Dangerous chemicals such as strong acids and alkalis must be stored at floor level; chemicals which are likely to react with each other must be stored well apart; poisons should be stored in locked cabinets. Manufacturers’ product safety data sheets must be checked for advice on safe handling of any potentially toxic or carcinogenic substances. Such reagents must be stored in a secure place with restricted access; they should be handled only by experienced staff wearing protective clothing and weighing should be carried out in an air-flow cabinet at face velocity of around 0.8 m/s.
Eyewash Facilities
An eyewash station should be conveniently located where hazardous chemicals or biological materials are handled. This should consist of a spray device attached to the water supply by a flexible hose. If access to plumbing is not available, the alternative is an ample supply of easy-to-open containers of water.
Biohazardous Specimens
When handling blood, the most commonly encountered pathogens are HIV and hepatitis viruses. All specimens of human origin should be regarded as potentially infectious and must be handled appropriately by means of universal precautions in order to minimize exposure of skin and mucous membranes to the hazard. Special precautions are necessary with highly infectious specimens (see below).
Universal Precautions
Disinfectants
There are several types of chemical which have been used as germicides, including aldehydes, phenols, halogens, alcohols and hypochlorites. However, some of these are no longer available in laboratories. Those that are now used are indicated in Table 24.10. No single disinfectant is effective against all pathogens and their effectiveness depends on the nature of the organism.47,50
Sodium hypochlorite (chlorine)
This is the most commonly used disinfectant in the laboratory as it is very active against all microorganisms, although less active against fungi. Its disadvantage is that it is corrosive to metal. As hypochlorite solutions gradually lose their strength, fresh dilutions must be made daily. For general use, a concentration of 1 g/l (1000 ppm) as available chlorine is required; a stronger solution containing 5 g/l (5000 ppm) is necessary for dealing with blood spillage.
Household bleaches usually contain 50 g/l as available chlorine and should thus be diluted 1:50 for general use and 1:10 for blood contamination. Other chlorine-containing compounds which can be used are prepared as follows:
Alcohols
Ethanol and isopropyl alcohol have similar disinfectant properties at a concentration of 70–80% in water; higher or lower concentrations reduce their germicidal effectiveness. They are active against vegetative bacteria and lipid viruses but not against spores or fungi. Their effect on non-lipid viruses is variable. Alcohol is especially effective when mixed with other agents (e.g. 80% alcohol with 100 g/l of formaldehyde or with 2 g/l (2000 ppm) available chlorine).
Applications of Disinfectants
Routinely, on completion of the day’s work, the working area should be wiped with a freshly prepared 1% w/v sodium hypochlorite solution (chlorine bleach). Reusable pipettes should be soaked in a 2.5% solution for 30 min or longer. A 10% solution must be used for cleaning up blood spillage. The diluted sodium hypochlorite solution should be freshly made each day. It is helpful to add detergent to the solution as disinfectants are most active on clean surfaces. A stabilized blend of peroxide with surfactant and organic acids in a buffer system is available as a commercial product, ‘Virkon’ (Antec-DuPont). It appears to be effective as a general disinfectant for all hard surfaces, plastic and stainless steel laboratory equipment, medical instruments and laundry and also for absorbing spilled blood or other body fluids.
Automated equipment
Some automated equipment can be disinfected by flushing several times with 10% w/v sodium hypochlorite, followed by several flushes with water. Hypochlorite causes corrosion of metal surfaces. Other instruments have special requirements for decontamination; always refer to the manufacturer’s instructions.
Centrifuges
Laboratory centrifuges require particular attention. They should never be cleaned using hypochlorite solution or other metal corrosives. Any spillage of blood should be dealt with immediately and the bowl, head and buckets (including rubber pads) should be disinfected regularly (e.g. with 2% Virkon) and then rinsed with a detergent (e.g. Decon 90) or 70% ethanol. Special care is required when a glass or plastic tube breaks in a centrifuge (Table 24.11).
Table 24.11 Procedure for decontaminating a centrifuge after breakage of a tube
| 1. | Switch off centrifuge motor and do not open lid for 1 h to allow aerosols to settle. Inform the safety officer. |
| 2. | When breakage involves a known high-risk specimen in a sealed bucket, strong gloves, goggles and a protective apron must be worn and the bucket opened in a safety cabinet. |
| 3. | If the leakage was confined to a sealed bucket, manually open the centrifuge and, using forceps to remove broken tubes and any solid debris, discard the contents of the bucket into 2% Virkon. |
| 4. | Decontaminate the inside of the lid, bowl and external surfaces of the buckets with 2% Virkon, rinse with Microsol 3+ (Analis, Belgium) or a detergent such as Decon 90 or 70% ethanol and leave to dry. |
| 5. | Buckets, rotors and other small centrifuge items may be autoclaved where appropriate. Alternatively, more delicate items (e.g. whole microfuges) may be fumigated within a safety cabinet. |
| 6. | All contaminated disposable material must be placed in appropriate bags for autoclaving. |
Syringes and needles
Although single-use disposable syringes and needles are strongly recommended, circumstances may require reusables. These must be washed thoroughly in running water to remove all traces of blood. Syringes are then soaked for at least 30 min and needles overnight in 10% hypochlorite bleach. They are then rinsed under running tap water and soaked in two changes of distilled or deionized water. Finally, before reuse, they must be sterilized by heating in an oven at 120°C for 30 min.
Gloves
Disposable gloves must not be reused as they may retain contaminated material and may deteriorate when cleaned. Rubber household gloves may be washed and decontaminated by soaking in 1% hypochlorite solution for 30 min, but they must be discarded if they have punctures or tears or if they show signs of deterioration such as peeling or cracking.
Laundry
Soiled laundry must be placed in leak-proof labelled bags for transport to the laundry where the items should be washed in hot water (>70°C) with detergent for 25–30 min before being rinsed or alternatively soaked in 1% w/v sodium hypochlorite solution (see above) before being washed by hand.
Waste Disposal
The safe disposal of laboratory waste is of prime importance. Laboratory waste and contaminated materials presents a health hazard both to laboratory workers and to the community. The careless dumping of solid and liquid chemical and biological waste is also a threat to the environment. WHO has a useful website (www.healthcarewastemanagement.org) which provides up-to-date information on various aspects of waste management, including country-specific and region-specific problems and legal requirements.
Laboratory waste is classified under the following headings:
Blood and other potentially infected body fluids can be poured down a drain safely only if it is connected to a sanitary sewer. The drain should then be immediately flushed with water, followed by 250 ml of 10% hypochlorite and finally again flushed with water. In the absence of a sewer system, the material should be ducted into holding tanks for steam heating or chemical treatment before final discharge to the public sewers. Specimen containers, used syringes, swabs and tissues should be collected in special colour-coded bags for subsequent incineration or autoclaving before being disposed of in a rubbish dump. ‘Sharps’ containers should be incinerated without opening.
Highly infectious specimens require special management:
Information about the disposal of specific chemicals is usually given in the manufacturer’s safety data sheet and a waste control strategy should be established, taking account of toxic and carcinogenic materials, corrosive substances, flammable substances and reactive chemicals with risk of explosion. Analyser effluents which do not contain chemicals that potentially react with metal waste piping can be discharged directly into a main sewer.
Pressurized containers must not be punctured or incinerated. They should be carefully discharged in the open air away from people and then discarded in non-hazardous waste containers.
General waste includes office and domestic material, paper and packaging and other substances not hazardous to human health. This may either be incinerated or disposed of according to local facilities.
Specimen Shipping
There are strict national and international regulations about packaging and shipment of patients’ specimens and other biological material by post or air transport; these also apply to courier services.51,52 The International Air Transport Association (IATA) requires that specimens must be packaged in accordance with requirements described on their website.
The following is a summary of the requirements:
When plasma or serum must be maintained in a frozen state, the packed specimen should be placed in an insulated container surrounded by dry ice. Conversely, care must be taken to prevent freezing of whole blood specimens. The container must also permit release of CO2 gas to prevent build-up of pressure. Specific airline regulations should be checked to ensure that dry ice is not deemed to be a hazardous material.
1 Stanfliet J.C., Macauley J., Pillay T.S. Quality of teaching in chemical pathology; ability of interns to order and interpret. J Clin Pathol. 2009;62:664-666.
2 Stuart J., Hicks J.M. Good laboratory management: an Anglo-American perspective. J Clin Pathol. 1991;44:793-797.
3 Delost M.D., Miller W.G., Chang G.A., et al. Influence of credentials of clinical pathology professionals on proficiency testing performance. Am J Clin Pathol. 2009;132:550-554.
4 College of American Pathologists Workload and Personnel Management Committee. Workload Recording Method and Personnel Management Manual. College of American Pathologists. Northfield, IL: USA, 1992.
5 Bennett C.H. Welcan UK: its development and future. J Clin Pathol. 1991;44:617-620.
6 Macdonald A.J., Bradshaw A.E., Holmes W.A., et al. The impact of an integrated haematology screening service on laboratory practice. Clin Lab Haematol. 1996;18:271-276.
7 International Organization for Standardization. Accuracy (trueness and precision) of measurement, methods and results. ISO 5725 Parts 1–4. Geneva: ISO, 1994.
8 Ellison S.L.R., Rosslein M., Williams A. Quantifying uncertainty in analytic measurement, 2007. Download from Eurachem-CITACGuide. 2007
9 Wagar E.A., Friedberg R.C., Souers R., et al. Critical values comparison: A College of American Pathologists Q-probes survey of 163 clinical laboratories. Arch Pathol Lab Med. 2007;131:1769-1775.
10 Viljoen A., Twomey P.J. True or not: uncertainty of laboratory results. J Clin Pathol. 2007;60:587-588.
11 Galen R.S., Gambino S. Beyond Normality: the Predictive Value and Efficiency of Medical Diagnoses. New York: Wiley, 1975.
12 Griner P.F., Nayawski R.J., Mushlin A.I., et al. Selection and interpretation of diagnostic tests and procedures: principles and applications. Ann Intern Med. 1981;94:553-592.
13 Youden W.J. Index for rating diagnostic tests. Cancer. 1950;3:32-35.
14 Hernandez J.S. Cost-effectiveness of laboratory testing. Arch Pathol Lab Med. 2003;127:440-445.
15 van Walraven C., Naylor C.D. Do we know what inappropriate laboratory utilization is? A systematic review of laboratory clinical audits. J Am Med Assoc. 1998;280:550-558.
16 International Council for Standardization in Haematology. Guidelines for the evaluation of blood cell analysers including those used for differential leucocyte and reticulocyte counting and cell marker applications. Clin Lab Haematol. 1994;16:157-174.
17 Henry J.B., Kelly K.C. Comprehensive graphic-based display of clinical laboratory data. Am J Clin Pathol. 2003;119:330-336.
18 Kiley R. Medical Information on the Internet: a Guide for Health Professionals, 3rd ed., Edinburgh: Churchill Livingstone, 2003.
19 Narayanan S. The preanalytic phase: an important component of laboratory medicine. Am J Clin Pathol. 2000;113:429-452.
20 Fraser C.G., Woodford F.P. Strategies to modify the test-requesting patterns of clinicians. Ann Clin Biochem. 1987;24:223-231.
21 Mutimer D., McCauley B., Nightingale P., et al. Computerised protocols for laboratory investigation and their effect on use of medical time and resources. J Clin Pathol. 1992;45:572-574.
22 Wagar E.A., Stankovic A.K., Raab S., et al. Specimen labeling errors: A Q-probes analysis of 147 clinical laboratories. Arch Pathol Lab Med. 2008;132:1617-1622.
23 Lippi G., Blanckaert N., Bonini P., et al. Causes, consequences, detection and prevention of identification errors in laboratory diagnostics. Clin Chem Lab Med. 2009;47:143-153.
24 Kratz A., Salem R.O., Van Cott E.M. Effects of a pneumatic tube system on routine and novel hematology and coagulation parameters in healthy volunteers. Arch Pathol Lab Med. 2007;131:293-296.
25 Wallin O., Söderberg J., Grankvist K., et al. Preanalytical effects of pneumatic tube transport on routine haematology, coagulation parameters, platelet function and global coagulation. Clin Chem Lab Med. 2008;46:1443-1449.
26 Graham E. An episode of increased hemolysis due to a defective pneumatic air tube delivery system. Clin Biochem. 2009;42:1265-1269.
27 Wagar E.A., Friedberg R.C., Souers R., et al. Critical values comparison: A College of American Pathologists Q-probe survey of 163 clinical laboratories. Arch Pathol Lab Med. 2007;131:1769-1775.
28 Piva E., Sciacovelli M., Laposata M., et al. Evaluation of effectiveness of a computerized notification system for reporting critical values. Am J Clin Pathol. 2009;131:432-441.
29 McLean R., Jury C., Bazeos A., et al. Application of camera phones in telehaematology. J Telemed Telecare. 2009;15:339-343.
30 Winkelman J.W., Tansijevic M.J., Wynbenga D.R., et al. How fast is fast enough for clinical laboratory turnabout time? Measurement of the interval between result entry and inquiries for reports. Am J Clin Pathol. 1997;108:400-405.
31 Valenstein P.N. Laboratory turnaround time. Am J Clin Pathol. 1996;105:676-688.
32 Hillbourne L., Lee H., Cathcart P. STAT testing? A guideline for meeting clinician turnaround time requirements. Am J Clin Pathol. 1996;105:671-675.
33 Valenstein P.N., Wagar E.A., Stankovic A.K., et al. Notification of critical results: A College of American Pathologists Q-probes study of 121 institutions. Arch Pathol Lab Med. 2008;132:1862-1867.
34 Briggs C., Guthrie D., Hyde K., et al. Guidelines for point-of-care testing: Haematology. Br J Haematol. 2008;142:904-915.
35 Briggs C., Carter J., Lee S.-H., et al. ICSH guidelines for worldwide point-of-care testing in haematology with special reference to the complete blood count. International Journal of Laboratory Hematology. 2008;30:105-116.
36 Medical Devices Agency. Management and Use of IVD Point-of-Care Test Devices. London: MDA, UK Department of Health, 2002.
37 Clinical and Laboratory Standards Institute, 2nd ed. Point-of-Care in vitro Diagnostic (IVD) Testing; Approved Guidelines, Vol 26. CLSI, Wayne, PA, USA, 2006. No 30
38 International Standards Organization. ISO 22870: Point-of-care testing (POCT) – requirements for quality and competence. Geneva: ISO, 2006.
39 Rose P.E., Fitzmaurice D. New approaches to the delivery of anticoagulant services. Blood Rev. 1998;12:84-90.
40 Ansell J.E., Patel N., Ostrovsky D., et al. Long-term patient self-management of oral anticoagulation. Arch Intern Med. 1995;155:2185-2189.
41 Erasmus R.T., Zemlin A.E. Clinical audit in the laboratory. J Clin Pathol. 2009;62:593-597.
42 Clinical Laboratory Improvement Amendments (CLIA’88). Code of Federal Regulations: Laboratory Requirements. USA: Atlanta, GA, 10/2004;967. Federal register Part 493, CDC
43 College of American Pathologists. Standards for laboratory accreditation. Northfield, IL, USA: College of American Pathologists, 1998.
44 Galloway M., Nadin L. Benchmarking and the laboratory. J Clin Pathol. 2001;54:590-1559.
45 International Electrotechnical Commission. Safety Requirements for Electrical Equipment for Measurement, Control and Laboratory Use: Part 1: General Requirements IEC/ISO/EN 61010. Geneva: ISO, 2001. [Other sections of this standard relate to particular requirements, e.g. Part 020: laboratory centrifuges; Part 081: semi-automated analysers; Part 101 in vitro diagnostic (IVD) medical equipment]
46 World Health Organization. Safety in Health-care Laboratories. Geneva: WHO, 1997. Document LAB/97.1
47 World Health Organization. Laboratory Biosafety Manual, 3rd ed., Geneva: WHO, 2004.
48 United Kingdom Health and Safety Executive. Safe Working and the Prevention of Infections in Clinical Laboratories. Sudbury, Suffolk, UK: HSE Books, 1991.
49 Holt A. Principles of Health and Safety at Work, 6th ed., Wigston, UK: Institute of Occupational Safety and Health, 2002.
50 Gardner J.F., Peel M.M. Sterilization, Disinfection and Infection Control, 3rd ed., London: Churchill Livingstone, 1998.
51 Nations United. Recommendations on the Transport of Dangerous Goods. Model Regulations, 15th ed., New York and Geneva: United Nations, 2007.
52 European Committee for Standardization. EN 829: Transport Packages for Medical and Biological Specimens – Requirements, Tests. Brussels: CEN, 1996.
* Irritant reactions to latex rubber or plastic gloves may be due to mechanical friction of the skin from poor fitting, prolonged use without changing the gloves, perspiration or a specific allergy. Handwashing with a mild antiseptic soap and application of an anti-inflammatory hand cream may be helpful. It may also be helpful to wear powder-free gloves and to wear a larger-sized glove to increase air circulation until the hands heal. In the event of a specific allergy to the chemical ingredients within the gloves, it may be worthwhile trying a different type or brand of glove.
Chapter 24 Laboratory organization and management
The essential functions of a haematology laboratory are (1) to provide clinicians with timely, unambiguous and meaningful reports to assist in the clinical diagnosis of disease and to monitor response to treatment; (2) to obtain reliable and reproducible data for health screening and epidemiological studies; and (3) to keep abreast with advancing technology as well as aspects of healthcare legislation that might be relevant to modern laboratory practice. The laboratory should also be involved in both the pre-analytical stage (i.e. test ordering, blood collection, specimen transport) and the post-analytical stage (i.e. preparing reports, transmission of results and maintaining a data file).
For good laboratory practice, it is essential to have a well-structured organization with competent direction and management. The principles outlined in this chapter apply to all laboratories, irrespective of their size, although large departments are likely to require the more complex arrangements that are described.
Management structure and function
The management structure of a haematology laboratory should indicate a clear line of accountability of each member of staff to the head of department. In turn, the head of department may be managerially accountable to a clinical director (of laboratories) and thence to a hospital or health authority executive committee. The head of department is responsible for departmental leadership, for ensuring that the laboratory has authoritative representation within the hospital and for ensuring that managerial and administrative tasks are performed efficiently. Where the head of the department delegates managerial tasks to others, these responsibilities must be clearly defined and stated. Formerly, the director was usually a medically qualified haematologist, but nowadays in many laboratories, this role is being undertaken by appropriately qualified biomedical scientists, while medical haematologists serve as consultants. In that role, they should be fully conversant with the principles of laboratory practice, especially with interpretation and clinical significance of the various analytical procedures, so as to provide a reliable and authoritative link between laboratory and clinic. Furthermore, all medical staff, especially junior hospital doctors, should be invited to visit the laboratory, to see how it functions, how various tests are performed, their level of complexity, clinical utility and cost: this should give them confidence to order tests rationally, rather than automatically requesting all the tests listed on the laboratory request form.1
Management of the laboratory requires an executive committee answerable to the head of department. Under this executive, there should be a number of designated individuals responsible for implementing the functions of the department (Table 24.1).
Table 24.1 Example of components of a management structure
| Executive committee | |
| Head of department | |
| Business manager | |
| Consultant haematologist | |
| Principal scientific officer | |
| Safety officer | |
| Quality control officer | |
| Computer and data processing supervisor | |
| Sectional scientific/technical heads | |
| Cytometry | |
| Blood film morphology | |
| Immunohaematology | |
| Haemostasis | |
| Blood transfusion | |
| Special investigations (haemolytic anaemias, haemoglobinopathies, cytochemistry, molecular techniques, etc.) | |
| Clerical supervisor | |
The activities of the various members of staff clearly overlap and there must be adequate effective communication between them. There should be regular briefings at meetings of technical heads, with their section staff. The only way to avoid unauthorized ‘leakage’ of information from policy-making committees is to ensure that all members of staff are kept fully informed of any plans which might have a bearing on their careers, working practices and wellbeing.
In many countries, there are now requirements established by regulatory agencies for accreditation of laboratories and audit of their performance, as well as documents on laboratory management and practice from standards-setting authorities; there is also a plethora of guidelines from national and international professional bodies. These may indicate a need for a special sub-committee of the executive committee, whose duty it is to keep abreast of these matters, to be responsible for developing standard operating procedures (SOPs) and to inter-relate with the different sections in the same way as the safety officer.
Staff Appraisal
All members of staff should receive training to enhance their skills and to develop their careers. This requires setting of goals and regular appraisal of progress for both managerial and technical ability. The appraisal process should cascade down from the head of department and appropriate training must be given to those who undertake appraisals at successive levels. The appraiser should provide a short list of topics to the person to be interviewed, who should be encouraged to add to the list, so that each understands the items to be covered. Topics to be considered should include: quality of performance and accurate completion of assignments; productivity and dependability; ability to work in a team; and ability to relate to patients, clinicians and co-workers. It is not appropriate to include considerations relating to pay. An appraisal interview should be a constructive dialogue of the present state of development and the progress made to date; it should be open-ended and should identify future training requirements. Ideally, the staff members should leave the interviews with the knowledge that their personal development and future progress are of importance to the department; that priorities have been identified; that an action plan with milestones and a time scale has been agreed; and that progress will be monitored. Formal appraisal interviews (annually for senior staff and more often for others) should be complemented by less formal follow-up discussions to monitor progress and to check that suboptimal performance has been modified. Documentation of formal interviews can be limited to a short list of agreed objectives. Performance appraisal can have lasting value in the personal development of individuals, but the process can easily be mishandled and should not be started without training in how to hold an appraisal interview.2
Continuing Professional Development
Continuing professional development is a process of continuous systematic learning which enables health workers to be constantly brought up to date on developments in their professional work and thus ensure their competence to practice throughout their professional careers. Policies and programmes have been established in a number of countries and, in some, participation is a mandatory requirement for the right to practice.3
In the UK, clinical haematologists and clinical scientists who have the relevant qualifications awarded by the Royal College of Pathologists (RCPath) and are licenced to practice by the General Medical Council, are required to participate in a scheme organized by the College. This involves maintenance of a portfolio showing their participation in relevant educational and academic affairs and demonstrations of their professional skills.
The Institute for Biomedical Science undertakes a similar scheme for scientists/technologists working in the laboratory, which is mandatory for registration to practice by the UK Health Professions Council. The procedure is based on obtaining ‘credits’ for various activities that qualify, such as: attendance at specified lectures, workshops and conferences; giving lectures; writing books or journal articles; using computer or journal-based programmes; and taking part in peer review discussions.
Strategic and Business Planning
The head of department is responsible for determining the long-term (usually up to 5 years) strategic direction of the department. Strategic planning requires awareness of any national and local legislation that may affect the laboratory and of changes in local clinical practice that may alter workload. Expansion of a major clinical service, such as organ transplantation, or the opportunity to compete for the laboratory service of other hospitals and clinics, may pose an external opportunity, but may also be a threat to the laboratory, depending on its ability to respond to the consequential increase in workload. Technical or scientific expertise would be a strength, whereas a heavy workload, without adequate staffing or lack of automation for routine tests, is likely to preclude any additional developmental work and would, thus, be a weakness.
Increasingly, laboratories must meet financial challenges and the need for greater cost-effectiveness. This may require rationalization by eliminating unused laboratory capacity, avoiding unnecessary tests and ensuring more efficient use of skilled staff and expensive equipment. This may require centralization of multiple laboratory sites or, conversely, there may be advantages in establishing satellite centres for the benefit of patients and clinicians if these can be shown to be cost-effective. Account must also be taken of the role of the laboratory in supervision of the extra-laboratory point-of-care procedures that have become increasingly popular.
A business plan is primarily concerned with determining short-term objectives that will allow the strategy to be implemented over the next financial year or so. It requires prediction of future work level and expansion. Planning of these objectives should involve all staff because this will heighten awareness of the issues and will develop personal concern in the strategy. In all but the smallest laboratory, a business manager is required to coordinate such planning and to liaise with the equivalent business managers in other clinical and laboratory areas.
Workload Assessment and Costing of Tests
Laboratories should maintain accurate records of workload, overall costs and the cost per test in order to apportion resources to each section. Computerization of laboratories has greatly facilitated this process. In assessing workload, account must be taken of the entire cycle from test receipt to issue of a report, whether the test is by a manual or semi-automated method or by a high-volume multiple-analyte automated analyser. Apportioning of resources should also take account of the roles of biomedical scientists/senior technologists and junior technicians, supervised laboratory assistants, clerical staff and medical personnel responsible for reviewing the report. Out of hours service requires a different calculation of costs.
Methods were developed for determining the workload and costs for various laboratory tests taking account of test complexity, total number of tests performed, quality control procedures, cost of reagent and use of material standards so that laboratories could compare their operational productivity with a peer group of participating laboratories. A good example is given on the website Standards for Management Information Systems in the Canadian Health Service Organizations.
A similar workload recording method was published by the College of American Pathologists,4 and the Welcan system was established in the UK.5 However, more recently, benchmarking schemes have been established that take account of productivity, cost-effectiveness and utilization compared with a peer group. The College of American Pathologists created their Laboratory Management Index Program in which participants submit their laboratories operating data on a quarterly basis and receive peer comparison reports from similar laboratories around the country by which their own cost-effectiveness can be evaluated.
Financial Control
Full costing of tests includes all aspects of laboratory function (Table 24.2).
Table 24.2 Factors contributing to cost of laboratory tests
| Direct costs | |
| Staff salaries | |
| Laboratory equipment purchases | |
| Reagents and other consumables | |
| Equipment maintenance | |
| Standardization and quality control | |
| Specific technical training on equipment | |
| Indirect costs | |
| Capital costs and mortgage factor | |
| Depreciation | |
| Building repairs and routine maintenance | |
| Lighting, heating and waste disposal | |
| Personnel services | |
| Cleaning services | |
| Transport, messengers and porters | |
| Laundry services | |
| Computers and information technology | |
| Telephone and fax | |
| Postage | |
| Journals and textbooks | |
The amount allocated for staff salaries should include the cost of training and should take into account absences for annual leave or sickness. It needs also to take into account the extent to which staff of various levels, as described earlier, are involved. Indirect costs may be apportioned to different sections of a department who share common overhead costs.
Calculation of Test Costs
When preparing a budget, the following formula provides a reasonably reliable estimate of the total annual costs:
where
Efficient budgeting requires regular monitoring, at least monthly. Computer spreadsheets provide an easily comprehended view of the financial state and the likely responses in the running of the laboratory.
In general, staff cost is by far the largest component of the total costs of running a laboratory. Furthermore, many of the other costs are obligations outside the direct control of the laboratory. If financial savings become necessary, they can be achieved in a variety of ways, but large savings usually necessitate a reduction in staff because employment costs can account for three-quarters of total expenditure. Possible initiatives include the following:
Increasingly, use of automated systems for routine screening tests allows the laboratory to consider staff reduction, although an estimate of savings must take account of capital, maintenance contracts and running costs of the equipment, especially the high cost of some reagents, and whether the system can be used to high capacity and throughout a 24 h service.
Purchasing expensive equipment outright adds to the capital assets of the laboratory, with the consequential cost of depreciation (usually 8–10% per annum). Leasing equipment can be a better alternative and, in many countries, most equipment is obtained in this way. Careful calculation of the lease cost is required because this can be up to 20% higher than outright purchase. An advantage of leasing is flexibility to upgrade equipment should workload increase or technology change. If maintenance and consumable costs are included in the same agreement, it may be possible to negotiate a reduction in charge for the consumables, but it is important to neither underestimate nor overestimate the annual requirements that will be included in the contract.
When automation is coupled with centralization of the service to another site, care must be taken to maintain service quality.6 Failure to do so will encourage clinicians to establish independent satellite laboratories. Loss of contact between clinical users and laboratory staff may compromise the pre-analytical phase of the test process and may lead to inappropriate requests, excessive requests and test samples that are of inadequate volume or are poorly identified. When services are centralized, attention must be paid to all phases (pre-analytical, analytical and post-analytical) of the test process, including the need for packaging the specimens and the cost of their transport to the laboratory.6
Test reliability
The reliability of a quantitative test is defined in terms of the uncertainty of measurement of the analyte (sometimes referred to in documents as ‘measurand’). This is based on its accuracy and precision.7
Accuracy is the closeness of agreement between the measurement that is obtained and the true value; the extent of discrepancy is the systematic error or bias. The most important causes of systematic error are listed in Table 24.3. The error can be eliminated or at least greatly reduced by using a reference standard with the test, together with internal quality control and regular checking by external quality assessment (see Chapter 25, p. 594).
Table 24.3 Systematic errors in analyses
| Analyser calibration uncertain (no reference standard available) |
| Bias in instrument, equipment or glassware |
| Faulty dilution |
| Faults in the measuring steps (e.g. reagents, spectrometry, calculations) |
| Sampling not representative of specimen |
| Specimens not representative of in vivo status (Ch. 1, p. 3) |
| Incomplete definition of analyte or lack of critical resolution of analyser |
| Approximations and arbitrary assumptions inherent in analyser’s function |
| Environmental effects on analyser |
| Pre-analytical deterioration of specimens |
Precision is the closeness of agreement when a test is repeated a number of times. Imprecision is the result of random errors; it is expressed as standard deviation (SD) and coefficient of variation (CV%). When the data are spread normally (Gaussian distribution), for clinical purposes, there is a 95% probability that results that fall within a range of +2SD to −2SD of the target value are correct and a 99% probably if within the range of +3SD to −3SD (see also Fig. 2.1).
Some of the other factors listed in Table 24.3 can be quantified to calculate the combined uncertainty of measurement. Thus, for example, when a calibration preparation is used, its uncertainty is usually stated on the label or accompanying certificate. The standard uncertainty is then calculated from the sum of the quantified uncertainties as follows:
Expanded uncertainty of measurement takes account of non-quantifiable items by multiplying the previous amount by a ‘coverage factor’ (k), which is usually taken to be ×2 for 95% level of confidence.7,8
It may be necessary to decide by statistical analysis whether two sets of data differ significantly. The t-test is used to assess the likelihood of significant difference at various levels of probability by comparing the means or individually paired results. The F-ratio is useful to assess the influence of random errors in two sets of test results (see Appendix, p. 625).
Of particular importance are reports with ‘critical laboratory values’ that may be indicative of life-threatening conditions requiring rapid clinical intervention. Haemoglobin concentration, platelet count and activated partial thromboplastin time have been included in this category.9 The development of critical values should involve consultation with clinical services.
Test selection
It is important for the laboratory to be aware of the limits of accuracy that it achieves in its routine performance each day as well as day-to-day.10 Clinicians should be made aware of the level of uncertainty of results for any test and the potential effect of this on their diagnosis and interpretation of response to treatment (see below).
To evaluate the diagnostic reliability and predictive value of an individual laboratory test, it is necessary to calculate test sensitivity and specificity.11 Sensitivity is the fraction of true positive results when a test is applied to patients known to have the relevant disease or when results have been obtained by a reference method. Specificity is the fraction of true negative results when the test is applied to normals.
where TP = true positive; TN = true negative; FP = false positive; FN = false negative.
Overall reliability can be calculated as:
Sensitivity and specificity should be near 1.0 (100%) if the test is unique for a particular diagnosis. A lower level of sensitivity or specificity may still be acceptable if the results are interpreted in conjunction with other tests as part of an overall pattern. It is not usually possible to have both 100% sensitivity and 100% specificity. Whether sensitivity or specificity is more important depends on the particular purpose of the test. Thus, for example, if haemoglobinometry is required in a clinic for identifying patients with anaemia, sensitivity is important, whereas in blood donor selection, for selecting individuals who are not anaemic, specificity is more important.
Likelihood Ratio
The ratio of positive results in disease to the frequency of false-positive results in healthy individuals gives a statistical measure of the discrimination by the test between disease and normality. It can be calculated as follows:12
The higher the ratio, the greater is the probability of disease, whereas a ratio <1 makes the possibility of the disease being correctly diagnosed by the test much less likely. Conversely, the likelihood of normality can be calculated as:
An alternative method is that of Youden, which is obtained by calculating Specificity/(1 − Sensitivity).13 Values range between −1 and +1. With a positive ratio rising above zero towards +1 there is an increasing probability that the test will discriminate the presence of the specified disease and there is decreasing likelihood that the test is valid when the ratio falls from 0 to −1.
Receiver–Operator Characteristic Analysis
The relative usefulness of different methods for the same test or of a new method against a reference method can also be assessed by analysing the receiver–operator characteristics (ROC).12 This is demonstrated on a graph by plotting the true-positive rates (sensitivity) on the vertical axis against false-positive rates (1 − specificity) on the horizontal axis for a series of paired measurements (Fig. 24.1). Obviously, the ideal test would show high sensitivity (i.e. 100% on vertical axis), with no false positives (i.e. 0% on horizontal axis). Realistically, there would be a compromise between the two criteria, with test selection depending on its purpose, i.e. whether as a screening to exclude the disease in question or to confirm a clinical suspicion that the disease is present. In the illustrated case Test A is more reliable than Test B for both circumstances.
Test Utility
To ensure reliability of the laboratory service, tests with no proven value should be eliminated and new tests should be introduced only when there is independent evidence of technical reliability as well as cost-effectiveness.
For assessing cost-effectiveness of a particular test, account must be taken of (1) cost per test as compared with other tests that provide similar clinical information; (2) diagnostic reliability; and (3) clinical usefulness as assessed by the extent with which the test is relied on in clinical decisions, whether the results are likely to change the physician’s diagnostic opinion and the clinical management of the patient, taking account of disease prevalence and a specified clinical or public health situation. This requires audit by an independent assessor to judge what proportion of the requests for a particular test are actually used intelligently and what percentage are unnecessary or wasted tests.14,15 Information on the utility of various tests can also be obtained from benchmarking (see p. 579) and published guidelines. Examples of the latter are the documents published by the British Committee for Standards in Haematology (www.BCSHGuidelines.com). The realistic cost-effectiveness of any test may be assessed by the formula:
Economic aspects should also be considered when providing an automated total screening programme for every patient, in contrast to specifically selected tests. Thus, while many clinicians may not be familiar with all of the 12 or more parameters included in the blood count as reported routinely by modern automated analysers and in most cases, some of these measurements are unlikely to be clinically useful, nevertheless the ‘not-requested’ information may be provided at no extra cost and even significant saving of time in the laboratory.
Instrumentation
Equipment Evaluation
Assessment of the clinical utility and cost-effectiveness of equipment to match the nature and volume of laboratory workload is a very important exercise. Guidelines for evaluation of blood cell analysers and other haematology instruments have been published by the International Council for Standardization in Haematology.16 In the UK, appraisal of various items of laboratory equipment was formerly undertaken by selected laboratories at the request of the Department of Health’s Medical Devices Agency, subsequently renamed Medicines and Healthcare products Regulatory Agency (MHRA) and now replaced by the Centre for Evidence-based Purchasing (CEP). (Their reports can be accessed from the website: www.pasa.nhs.uk/ceppublications.)
Principles of Evaluation
The following aspects are usually included in evaluations:
After an instrument has been purchased and installed, it is useful to undertake regular less extensive checks of performance with regard to precision, linearity, carryover and comparability.
Precision
Carry out appropriate measurements 10 times consecutively on three or more specimens selected in the pathological range so as to include a low, a high and a middle range concentration of the analyte. Calculate the replicate SD and CV as shown on p. 625. The degree of precision that is acceptable depends on the purpose of the test (Table 24.4). To check between-batch precision, measure three samples in several successive batches of routine tests; calculate the SD and CV in the same way.
Linearity
Linearity demonstrates the effects of dilution. Prepare a specimen with a high concentration of the analyte to be tested and, as accurately as possible, make a series of dilutions in plasma so as to obtain 10 samples with evenly spaced concentration levels between 10% and 100%. Measure each sample three times and calculate the means. Plot results on arithmetic graph paper. Ideally, all points should fall on a straight line that passes through the zero of the horizontal and vertical axes. In practice, the results should lie within 2SD limits of the means calculated from the CVs, which have been obtained from analysis of precision (see earlier). Inspection of the graph will show whether there is linearity throughout the range or whether it is limited to part of the range.
Carryover
Carryover indicates the extent to which measurement of an analyte in a specimen is likely to be affected by the preceding specimen. Measure a specimen with a high concentration in triplicate, immediately followed by a specimen with a low concentration of the analyte:
where l1 and l3 are the results of the first and third measurements of the samples with a low concentration and h3 is the third measurement of the sample with a high concentration.
Accuracy and Comparability
Accuracy and comparability test whether the new instrument (or method) gives results that agree satisfactorily with those obtained with an established procedure and with a reference method. Test specimens should be measured alternately, or in batches, by the two procedures. If results by the two methods are analysed by correlation coefficient (r), a high correlation does not mean that the two methods agree. Correlation coefficient is a measure of relation and not agreement. It is better to use the limits of agreement method.12 For this, plot the differences between paired results on the vertical axis of linear graph paper against the means of the pairs on the horizontal axis (Fig. 24.2); differences between the methods are then readily apparent over the range from low to high values. If the scatter of differences increases at high values, logarithmic transformed data should be plotted.
Figure 24.2